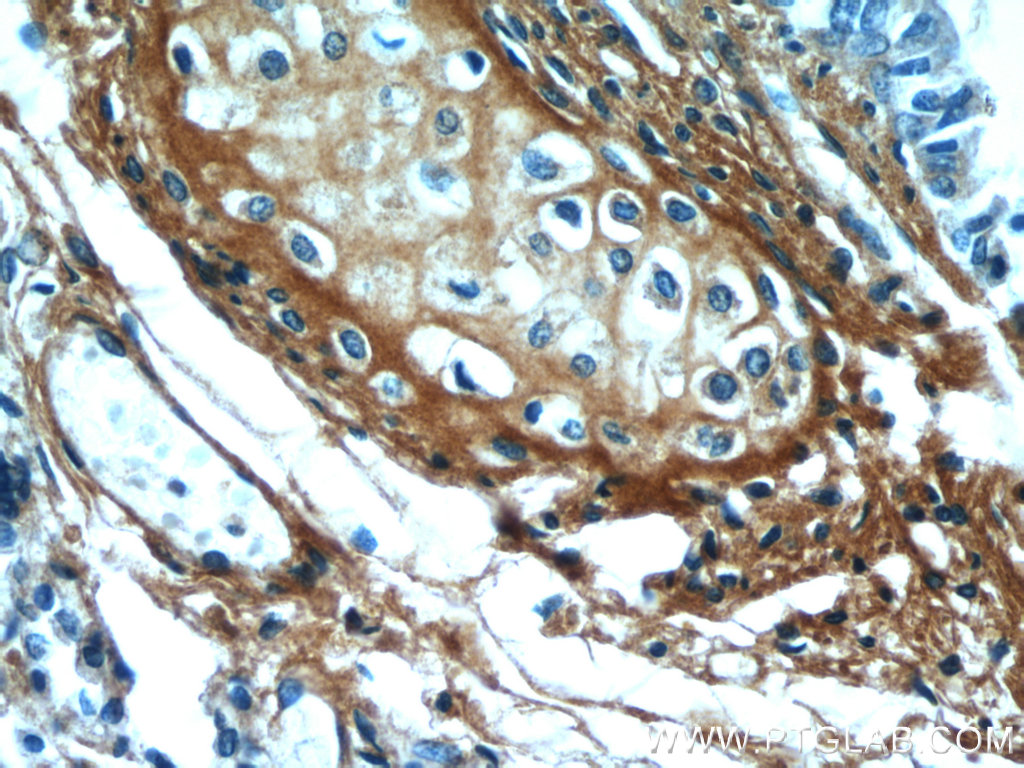

验证数据展示
经过测试的应用
| Positive WB detected in | NIH/3T3 cells, HeLa cells, human liver tissue |
| Positive IHC detected in | human lung tissue Note: suggested antigen retrieval with TE buffer pH 9.0; (*) Alternatively, antigen retrieval may be performed with citrate buffer pH 6.0 |
| Positive IF/ICC detected in | HepG2 cells |
推荐稀释比
| 应用 | 推荐稀释比 |
|---|---|
| Western Blot (WB) | WB : 1:500-1:2000 |
| Immunohistochemistry (IHC) | IHC : 1:20-1:200 |
| Immunofluorescence (IF)/ICC | IF/ICC : 1:200-1:800 |
| It is recommended that this reagent should be titrated in each testing system to obtain optimal results. | |
| Sample-dependent, Check data in validation data gallery. | |
产品信息
12755-1-AP targets Osteoglycin in WB, IHC, IF/ICC, ELISA applications and shows reactivity with human, mouse, rat samples.
| 经测试应用 | WB, IHC, IF/ICC, ELISA Application Description |
| 文献引用应用 | WB, IHC, IF |
| 经测试反应性 | human, mouse, rat |
| 文献引用反应性 | human, mouse |
| 免疫原 |
CatNo: Ag3484 Product name: Recombinant human OGN protein Source: e coli.-derived, PGEX-4T Tag: GST Domain: 1-298 aa of BC037273 Sequence: MKTLQSTLLLLLLVPLIKPAPPTQQDSRIIYDYGTDNFEESIFSQDYEDKYLDGKNIKEKETVIIPNEKSLQLQKDEAITPLPPKKENDEMPTCLLCVCLSGSVYCEEVDIDAVPPLPKESAYLYARFNKIKKLTAKDFADIPNLRRLDFTGNLIEDIEDGTFSKLSLLEELSLAENQLLKLPVLPPKLTLFNAKYNKIKSRGIKANAFKKLNNLTFLYLDHNALESVPLNLPESLRVIHLQFNNIASITDDTFCKANDTSYIRDRIEEIRLEGNPIVLGKHPNSFICLKRLPIGSYF 种属同源性预测 |
| 宿主/亚型 | Rabbit / IgG |
| 抗体类别 | Polyclonal |
| 产品类型 | Antibody |
| 全称 | osteoglycin |
| 别名 | OGN, SLRR3A, Osteoinductive factor, OIF, OG |
| 计算分子量 | 298 aa, 34 kDa |
| 观测分子量 | 34-40 kDa |
| GenBank蛋白编号 | BC037273 |
| 基因名称 | OGN |
| Gene ID (NCBI) | 4969 |
| RRID | AB_10646479 |
| 偶联类型 | Unconjugated |
| 形式 | Liquid |
| 纯化方式 | Antigen affinity purification |
| UNIPROT ID | P20774 |
| 储存缓冲液 | PBS with 0.02% sodium azide and 50% glycerol, pH 7.3. |
| 储存条件 | Store at -20°C. Stable for one year after shipment. Aliquoting is unnecessary for -20oC storage. |
背景介绍
This gene encodes a member of the small leucine-rich proteoglycan (SLRP) family of proteins. The encoded protein induces ectopic bone formation in conjunction with transforming growth factor beta and may regulate osteoblast differentiation. High expression of the encoded protein may be associated with elevated heart left ventricular mass. Alternative splicing results in multiple transcript variants which forms proteins with different molecular weight.
实验方案
| Product Specific Protocols | |
|---|---|
| IF protocol for Osteoglycin antibody 12755-1-AP | Download protocol |
| IHC protocol for Osteoglycin antibody 12755-1-AP | Download protocol |
| WB protocol for Osteoglycin antibody 12755-1-AP | Download protocol |
| Standard Protocols | |
|---|---|
| Click here to view our Standard Protocols |
发表文章
| Species | Application | Title |
|---|---|---|
J Hazard Mater Epigenetic reprogramming of HDAC2 in CA1 excitatory neurons determines Pb-induced non-spatial memory deficits | ||
J Inflamm Res The m6A/m1A/m5C-Related Methylation Modification Patterns and Immune Landscapes in Rheumatoid Arthritis and Osteoarthritis Revealed by Microarray and Single-Cell Transcriptome | ||
Sci Rep Proteomic profiling of concurrently isolated primary microvascular endothelial cells, pericytes, and vascular smooth muscle cells from adult mouse heart. | ||
Onco Targets Ther Osteoglycin (OGN) Inhibits Cell Proliferation and Invasiveness in Breast Cancer via PI3K/Akt/mTOR Signaling Pathway. | ||
Front Immunol Identification of nine signature proteins involved in periodontitis by integrated analysis of TMT proteomics and transcriptomics |